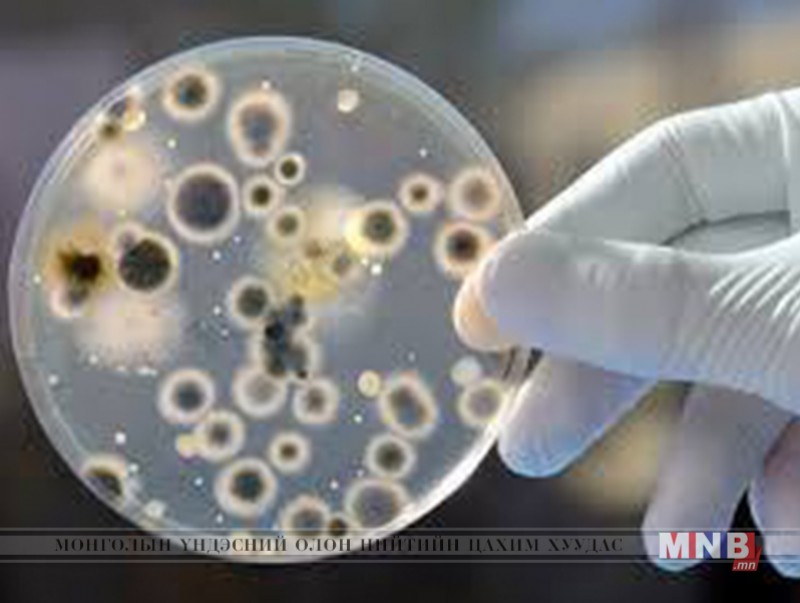

Дэлхийн дахинд жил бүр үр тариа, тосны ургамлын үрний ихээхэн хэсэг нь токсин ялгаруулдаг хөгцний мөөгөнцрөөр халдварлагдсаны уршгаар их хэмжээний хорогдол гардаг. Бүтээгдэхүүний алдагдлын хэмжээ АНУ-д 5 хувь орчим байдаг бол тропик, субтропикийн орнуудад 30 хувь хүрдэг байна.
Малын тэжээл хөгцний мөөгөнцрөөр халдварлагдсан тохиолдолд мөөгөнцрийн токсины нөлөөгөөр тэжээлийн найрлага өөрчлөгдөж шимт чанар нь буурдаг.
Түгээмэл тархалттай хөгц үүсгэгч мөөгөнцрүүдийн төрөл
Aspergillus: A.flavus A.niger, A.peniciloides A.wentii, A.restrictus F.strictum, A. canditus A.fumigators A.sydowii, A.versicolor, A.parasiticus A.ochraceus, A.ostianus, A.sydowii A.terreus, A.nidulans A.nigricans
Fusarium: F.moniliforme, F.graminearum, F. Proliferatum, F.culmorum, F. Solani, F.crookwellense, F.sporotrichioides, F.equiseti, F. longipes, F. oxysporum
Penicillium: P.werrucosum, P.citrinum, P.aurantiogriseum, P.funicolosum, P.olsonii, P. frequentanas
Бусад: Erotium spp, Cladiosporium spp, Alternaria spp
Мөөгөнцрийн бодисын солилцооны явцад үүссэн хүн, амьтанд хортой нөлөөтэй бодисыг микотоксин гэж нэрлэнэ.
Диоксинваленол /ниваленол: Диоксинваленол/ ниваленол - хүнсний бүтээгдэхүүнийг хордуулдаг микотоксиноос хамгийн өргөн тархсан. Үр тарианы ургамал тариалдаг бүх нутагт хөнөөл учруулдаг. Тэжээлээр дамжин гэрийн тэжээмэл амьтад ялангуяа гахайг хүчтэй хордуулна. Хордсон малын дархлаа суларч бактери, мөөгөнцөр, вирусын халдвар амархан авч өвчилнө. Диоксинваленолаар хордсон гахайнд хоолонд дургүй болох, бөөлжих, хээл хаях, хээлтүүлэх чадвар нь буурах зэрэг шинж тэмдэг илэрдэг. Үхэр харьцангуй тэсвэртэй боловч хордсон малын сүүний гарц буурч, хоолонд дургүй болдог.
Зеараленон: Зеараленон нь F.graminearum-аар өвчилсөн эрдэнэ шишийн үрэнд үүсдэг.
Микотоксиноор хордсон тэжээл идсэн гахайны сүүний булчирхай томрох, үр төл нь жижиг давжаа туниа муутай төрөх гэх зэргээр хордлогын шинж тэмдэг илэрдэг бол хордсон үнээний сүүний гарц мууддаг байна.
Очратоксин: A.ochraceus, Penicillium werrucosum, P.viridicatum, P.werrucosum мөөгөнцрөөр үүсдэг энэ токсиноор ихэвчлэн үр тарианы ургамлын үр хорддог. Тэжээмэл амьтдаас гахай энэ токсинд их мэдрэмтгий бөгөөд уг өвчин баруун Европын орнуудад нилээд үзэгддэг. Очратоксин А (ОТА) Элэг, бөөрийг гэмтээхээс гадна хорт хавдар үүсгэх шинж чанартай.
Афлатоксин: Aspergillus flavus мөөгөнцрөөр үүсдэг токсин. Тэжээмэл амьтдаас шувуу энэ токсинд их мэдрэмтгий. Афлатоксин В1 - C17H12O6 хорт хавдар үүсгэх шинж чанартай.
Фуманизин: Фуманизин В1-ийн томьёо- С34H59NO15 Fusarium moniliforme болон түүнтэй төстэй зүйлүүдээр үүсдэг. Байгалийн нөхцөлд эрдэнэ шиш энэ төрлийн токсиноор их бохирддог.
Эрготоксин: Эрготоксины томьёо- C35H41N5O6. Таримал болон зэрлэг үет ургамлыг өвчлүүлэгч Claviceps purpurea мөөгөнцөрөөс ялгардаг. Өвчилсөн ургамлын үрээр бэлтгэсэн гурил, гурилан бүтээгдэхүүн хордлого үүсгэх аюултай.
Эрготамин: Эрготамины томьёо- C33H35N5O6. Таримал болон зэрлэг үет ургамлыг өвчлүүлэгч Claviceps purpurea мөөгөнцрөөс ялгардаг. Өвчилсөн ургамлын үрээр бэлтгэсэн гурил, гурилан бүтээгдэхүүн хордлого үүсгэх аюултай. Эрготоксин, эрготамины төрлийн микотоксиноор үүсдэг өвчнийг эрготизм хэмээн нэрлэдэг. Уг өвчин дундад зууны үед Европын орнуудад гарч ихээхэн хор хохирол учруулж байсан гэдэг. Эрготизмын шинж тэмдэг халуурах, бөөлжих, татах, ходоод өвдөх байдлаар илэрдэг.
Харгаар өвчилсөн ургамал идсэн мал хордохоос гадна хээл хаядаг. Өвчний халдвар О.3 хувиас дээш тохиолдолд эрготизм үүсэх аюултай учир ийм будааг худалдах, хүн малын хүнс, тэжээлийн хэрэгцээнд хэрэглэхийг хориглодог.
Эх сурвалж: НМХГ
| Ургамлын гаралтай бүтээгдэхүүний хөгцрөлт ба микотоксин, түүнээс урьдчилан сэргийлэх арга | ||
| Үзсэн: 5151 | Mongolian National Broadcaster |


 Үндэсний телевиз
Үндэсний телевиз









































































































 Лханаагийн Мөнхтөр
Лханаагийн Мөнхтөр

 Р.Слава
Р.Слава

 Б.Цоожчулуунцэцэг
Б.Цоожчулуунцэцэг





Сэтгэгдэл бичих:
АНХААРУУЛГА: Уншигчдын бичсэн сэтгэгдэлд MNB.mn хариуцлага хүлээхгүй болно. ТА сэтгэгдэл бичихдээ хууль зүйн болон ёс суртахууны хэм хэмжээг хүндэтгэнэ үү. Хэм хэмжээг зөрчсөн сэтгэгдэлийг админ устгах эрхтэй. Сэтгэгдэлтэй холбоотой санал гомдолыг 70127055 утсаар хүлээн авна.